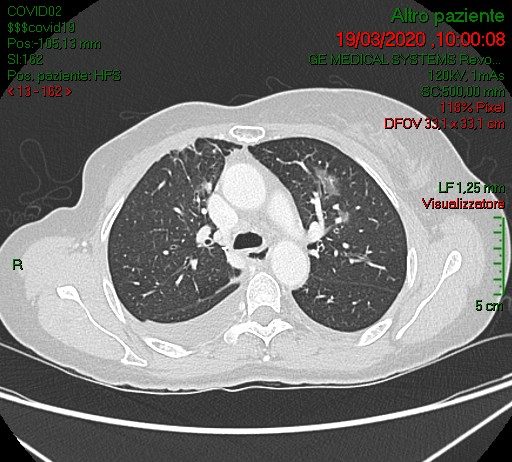
COVID-19: caso 69

R. Campa, A. Leonardi, Dott.sse V. Cristina, R. Occhiato, AOU Policlinico Umberto I - Sapienza Università di Roma, Dir. Prof. C. Catalano.
Paziente di 77 anni giunge per tosse e dispnea dal circa 5 giorni per cui ha assunto prima terapia con amoxicillina/ acido...
F. Maio, R. Blasio, M. Tanga, C. Rinaldo, P. Gagliardi, F. PintoUOC di Radiologia: Direttore: Dott. F. Pinto P.O. “Anastasia Guerriero” – Marcianise, ASL Caserta.
Paziente di 88 anni, maschio, accede al Pronto Soccorso del PO di Marcianise (direttore: Prof. M. Giordano) il 02/03/2020.
Sergio MargariASST Fatebenefratelli Sacco - MilanoRadiologia Fatebenefratelli
Maschio, 45 anni.Esegue come paziente ambulatoriale RX torace standard in due proiezioni:
plurimi addensamenti parenchimali peribroncovasali in sede perilare polmonare destra, nel campo polmonare...
Sergio MargariASST Fatebenefratelli Sacco - MilanoRadiologia Fatebenefratelli
Femmina, 58 anni, asintomatica e apiretica.Esegue come paziente ambulatoriale esterna TC total body per controllo oncologico in neoplasia mammaria, sottoposta nel 2006 a mastectomia con linfoadenectomia, trattata con CT neoadiuvante e RT.
Marta Brandani, Medico Radiologo, Ospedale Santa Maria alla Gruccia (Valdarno, Provincia di Arezzo)
Paziente maschio di 77 anni portato in PS dopo peggioramento clinico (difficoltà ad alimentarsi ed idratarsi) per diarrea, vomito ed epigastralgia da 15 gg. Il paziente condivide abitazione con soggetto...
Michele Pietragalla , Letizia Vannucchi , Luca Carmignani , Andrea Pagliari , Claudia Calabresi, Giuseppe Alabiso , Silvia Rossi , Anna Talina Neri , Michele Trezzi , Massimo Di Pietro
SOC Radiodiagnostica Ospedale San Jacopo PistoiaReparto Malattie Infettive Ospedale San Jacopo Pistoia
Izzo Andrea, D'Aversa Lucia, Cerimoniale Giuseppe, Mazzella Giuseppe, Pergoli Pericle, Faiola Eugenio Leone, Casale Lorenzo, Di Pastena Francesca
U.O.C. Diagnostica per immagini - Ospedale “Dono Svizzero” Formia DEA I livello– Asl Latina
Paziente Femmina, 71 anni, trasferita al DEA da PS del...
Izzo Andrea, D'Aversa Lucia, Cerimoniale Giuseppe, Mazzella Giuseppe, Pergoli Pericle, Faiola Eugenio Leone, Casale Lorenzo, Di Pastena Francesca
U.O.C. Diagnostica per immagini - Ospedale “Dono Svizzero” Formia DEA I livello– Asl Latina
Paziente Maschio, 74 anni, si presenta in PS per dolore...
Izzo Andrea, D'Aversa Lucia, Cerimoniale Giuseppe, Mazzella Giuseppe, Pergoli Pericle, Faiola Eugenio Leone, Casale Lorenzo, Di Pastena Francesca
U.O.C. Diagnostica per immagini - Ospedale “Dono Svizzero” Formia DEA I livello– Asl Latina
Paziente Maschio, 57 anni, trasportato dal 118 per febbre, tosse...
Izzo Andrea, D'Aversa Lucia, Cerimoniale Giuseppe, Mazzella Giuseppe, Pergoli Pericle, Faiola Eugenio Leone, Casale Lorenzo, Di Pastena Francesca
U.O.C. Diagnostica per immagini - Ospedale “Dono Svizzero” Formia DEA I livello– Asl Latina
Paziente Maschio, 49 anni, trasportato dal 118 in PS per...